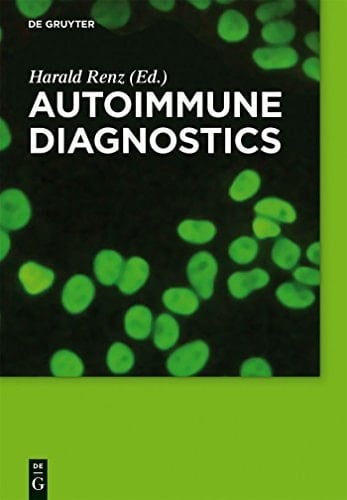
Autoimmune Diagnostics

Dieses Buch Führt Praxisnah Und Sicher Durch Die Komplexe Autoimmundiagnostik Und Die Diagnostischen Pfade. Es Bietet Einen Überblick über Die Wichtigsten Aspekte Der Autoimmundiagnostik, Eine Standardanleitung Zur Methodik Der Indirekten Immunfluoreszenz Und Beschreibt Prägnant Alle Wichtigen Autoimmunerkrankungen Hinsichtlich Ihrer Diagnose. Das Innovative Konzept Der Diagnostischen Pfade, Das In Deutschland Und International Zunehmend In Den Kliniken Angewandt Wird, Dient Hier Als Praktischer Wegweiser Für Den Kliniker Und Leitet Vom Symptom Durch Alle Schritte Und Verzweigungen Bis Hin Zur Diagnose. Die Ableitung Eines Diagnostischen Vorgehens über Einen Algorithmus Ist Verbindlich, Wird Vielerorts In Krankenhausinformationssysteme Implementiert, Fördert Die Verständigung Zwischen Klinik Und Labor Und Verhindert Fehldiagnosen. This Book Provides A Practical And Secure Guide Through The Complexity Of Autoimmune Diagnostics And Diagnostic Pathways. It Contains An Overview Of Significant Aspects Of Autoimmune Diagnostics, A Standard Procedure For Indirect Immunofluorescence And Describes All Important Autoimmune Diseases In Terms Of Their Diagnostic. In Step With Actual Practice The Innovative Concept Of Diagnostic Pathways Leads From Symptoms Through All Steps And Branches To Diagnosis. General Aspects Of Autoimmune Diagnostics -- Rheumatoid Arthritis -- Systemic Lupus Erythematosus -- Consensus Protocol For The Detection Of Autoantibodies By Indirect Immunofluorescence Technology On Hep-2 Cells -- The Antiphospholipid Syndrome -- Inflammatory Myopathies (polymyositis, Dermatomyositis) -- Systemic Sclerosis -- Autoimmune Blistering Disorders -- Autoimmune Liver Disease -- Autoimmunity In Diabetes Mellitus -- Autoimmune Thyroid Diseases -- Autoimmune Primary Adrenal Insufficiency -- Inflammatory Bowel Disease -- Celiac Disease -- Autoimmune Polyendocrine Syndromes. Edited By Harald Renz. Description Based Upon Print Version Of Record. Includes Bibliographical Refer
Page Count:
206
Publication Date:
2012-07-30
ISBN-10:
1283627477
ISBN-13:
9781283627474
No comments yet. Be the first to share your thoughts!